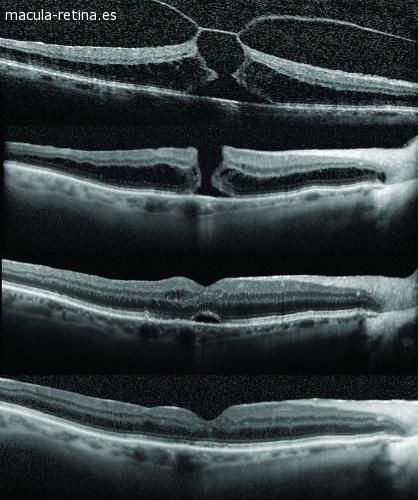

¿Qué es el agujero macular y cómo se trata? | Dra. Alicia Domínguez de Bareiro
En una nueva edición de Vivir Plenamente, nuestra médica oftalmóloga de confianza, Dra. Alicia Domínguez de Bareiro, respondió las dudas respecto al agujero macular, ¿Cuáles son los tipos más comunes? ¿Cómo se produce y cómo se puede prevenir? Bareiro explicó que el agujero macular es la presencia de una apertura...
En una nueva edición deVivir Plenamente, nuestra médica oftalmóloga de confianza,Dra. Alicia Domínguez de Bareiro, respondió las dudas respecto al agujero macular,¿Cuáles son los tipos más comunes? ¿Cómo se produce y cómo se puede prevenir?
Bareiro explicó que el agujero maculares la presencia de una apertura en la mácula, que es la zona central de la retina.Detalló que existen dos tipos principales:el agujero macular idiopático y el agujero macular miópico.
El primero, también llamado senil, “está relacionado con la edad del paciente, porque puede aparecer aproximadamente a partir de los 60 años”. En tanto que, sobre el segundo tipo, comentó que “ocurre en pacientes con alta miopía. Tiende a aparecer a una edad más temprana, y puede producir desprendimiento de retina”.
Respecto al porqué se produce este caso, Bareiro precisó que “se produce por una atracción del vítreo, que es la sustancia gelatinosa que ocupa el 80% del contenido del globo ocular. Al contraerse, tira el centro de la retina hacia delante hasta producir un agujero en la zona correspondiente al centro de la visión, y una vez que se desarrolla el agujero macular, la posibilidad de que se cierre espontáneamente es muy pequeña”.
¿Cómo se puede prevenir?
La Dra. Alicia Domínguez de Bareiro sostuvo que “los controles oftalmológicos regulares permiten detectar lesiones en la retina que generalmente son asintomáticos, por eso es muy importante que la población de riesgo, en este caso miopes altos y las personas con edad avanzada, se sometan a revisiones oftalmológicas completas como mínimo una vez al año”.
Además, explicó que la sintomatología generalmente es muy parecida a la degeneración macular: “el paciente puede sentir una pérdida de la visión central, es decir, nota muy borrosa las imágenes, porque solamente en la parte central, en la parte periférica, queda bien”.
Agregó que ven “deformaciones en las imágenes, esto es, las líneas la ven torcidas, o a veces falta directamente la visión central, tratándose de una ceguera justo bien en el centro de su visión”.
También detalló que en estos casos “el paciente, a veces, no se da cuenta de que tiene un agujero macular en un ojo, a no ser que se tape el ojo sano y note que la visión de su ojo afectado a disminuido,por eso es muy importante esta prueba muy sencilla de taparte primero un ojo y después el otro”.
Acerca del tratamiento
Nuestra oftalmóloga de confianza comentó que el tratamiento del agujero macular es quirúrgico: “las cirugías para estos casos generalmente, en un 95%, dan muy buen resultado, pero cuanto antes se realice la parte quirúrgica es mejor”.
Sin embargo, la profesional hizo hincapié en que “los agujeros maculares miópicos, en pacientes con alta miopía, el pronóstico suele ser un poco más complicado porque generalmente, si bien recuperan su visión, no es al 100%, porque no se cierran bien los agujeros y se puede producir desprendimiento de retina”.
La doctora concluyó en que lo más importante es consultar a su oftalmólogo periódicamente “porque es la única forma de detectar esta patología a tiempo”.